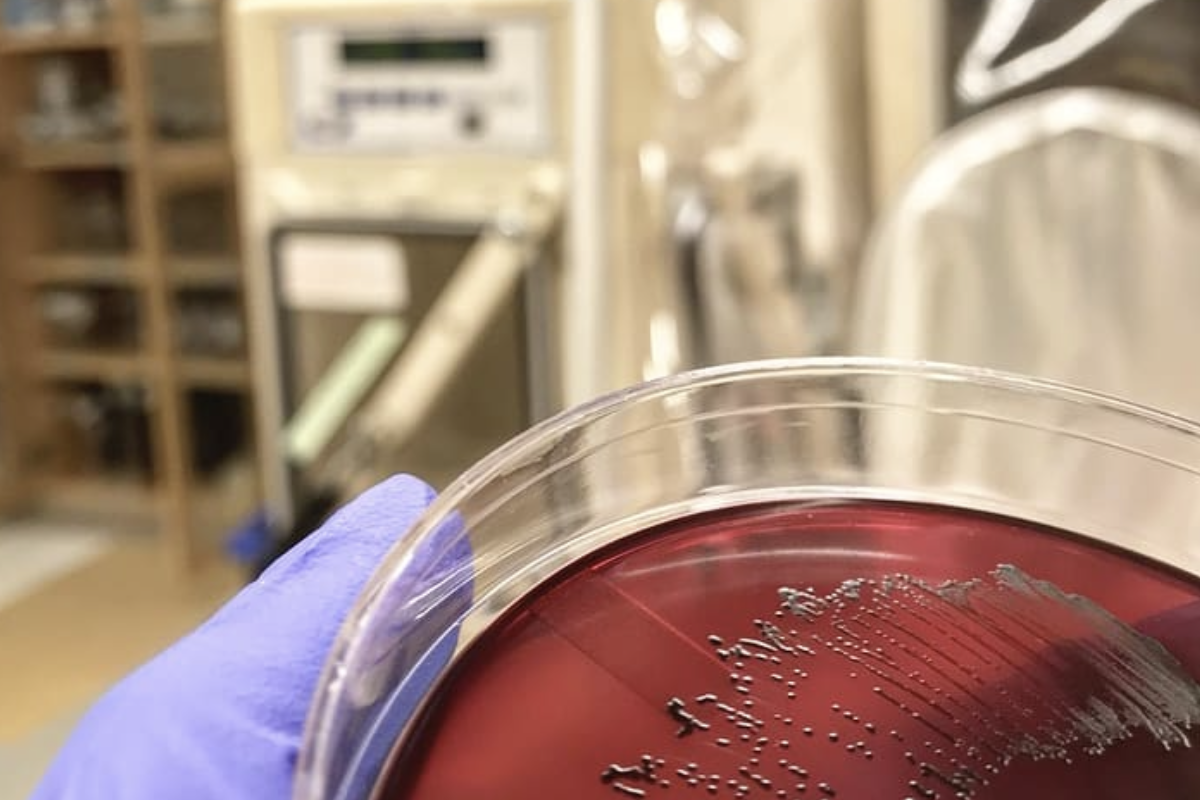

Poyet and Groussin labs
We combine computational and experimental investigations to understand host-microbiome interactions and evolution

RESSOURCES
..
Global Microbiome Conservancy
We aim to advance our knowledge of the human associated microbiomes and boost global research capacity.

Kiel Microbiome Center
We drive translational innovation to promote the health of humans, animals, plants and the environment.

NEWS